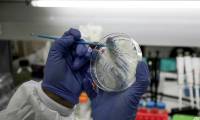
What if the world had not yet found the Covid-19 vaccine?

Article on the subject of "vaccine"
-

What is special about Russia's cancer vaccine?
what is so special about the russian cancer vaccine pembroria that it has been licensed for use in vietnam? the russian cancer vaccine has truly brought hope to those who are unfortunately suffering from terminal illnesses.
-

US: Breakthrough kidney cancer vaccine development
clinical trial results show that a vaccine against a factor called a neoantigen may help prevent the recurrence of kidney cancer.
-

Bill Gates anti-coronary vaccine may be available in 12 months
investing in all seven of the most feasible anti-covid-19 vaccine studies, the billionaire philanthropy has given the world hope for a pandemic once and for all.
-

What if the world had not yet found the Covid-19 vaccine?
the world is waiting for the vaccine against covid-19, but if that vaccine has not been found, will we have prepared plan b for such a future?
-

The 'Gamvid-19 vaccine gamble' and the memory of Vietnam's major breakthrough made WHO unbelievable
production of covid-19 vaccine will be risky. but we still have to do it so that if tomorrow, the covid-19 epidemic will regress or disappear, or the corona virus will return to the new strain, we still have a new technology to produce vaccines.
-

Canada tests new vaccine against SARS-CoV-2 virus
saskatchewan university of canada has now introduced the vaccine to the covid-19 virus into a formal test.
-

What is the HPV vaccine? Here's what you need to know about the HPV vaccine
the hpv 2026 vaccine will be included in the expanded immunization program for free. here's what you need to know about the hpv vaccine.
-

What is Rota Vaccine? Things to know about Rota Vaccine
rotavirus vaccines have been shown to be a cost-effective intervention that not only saves lives but also reduces the burden on families and the health system. here are some things to know about the rotavirus vaccine.
-

The 'Gamvid-19 vaccine gamble' and the memory of Vietnam's major breakthrough made WHO unbelievable
production of covid-19 vaccine will be risky. but we still have to do it so that if tomorrow, the covid-19 epidemic will regress or disappear, or the corona virus will return to the new strain, we still have a new technology to produce vaccines.
-

What is special about Russia's cancer vaccine?
what is so special about the russian cancer vaccine pembroria that it has been licensed for use in vietnam? the russian cancer vaccine has truly brought hope to those who are unfortunately suffering from terminal illnesses.
-

What if the world had not yet found the Covid-19 vaccine?
the world is waiting for the vaccine against covid-19, but if that vaccine has not been found, will we have prepared plan b for such a future?
-

US: Breakthrough kidney cancer vaccine development
clinical trial results show that a vaccine against a factor called a neoantigen may help prevent the recurrence of kidney cancer.
-

Canada tests new vaccine against SARS-CoV-2 virus
saskatchewan university of canada has now introduced the vaccine to the covid-19 virus into a formal test.
-

The United States first tested Covid-19 vaccine on humans today
in addition to the moderna vaccine that will begin testing today, inovio, an american pharmaceutical company, said it will also launch human trials of the vaccine against its sars-cov-2 virus. in april. there will be a few dozen volunteers at the university of pennsylvania and one trun
-

Bill Gates anti-coronary vaccine may be available in 12 months
investing in all seven of the most feasible anti-covid-19 vaccine studies, the billionaire philanthropy has given the world hope for a pandemic once and for all.
-

China says it will test the corona virus vaccine in April
china says the research process for the new corona virus vaccine is going smoothly and that it will begin clinical trials of the vaccine next month.
-

US scientists develop COVID-19 vaccine patch, using simple technology, easy to mass produce
test results for this vaccine on mice were published by lancet medical journal. this is the first published peer-reviewed covid-19 vaccine study - a gold standard for scientific research, and the authors of the paper said they could go faster than research groups.
-

Video: Experience of the first person in the world to be tested on Covid-19 vaccine
jennifer haller was the first volunteer to get the covid-19 vaccine. she is now a mother with two children. haller said his children found their mothers taking part in a vaccine test similar to signing up for an interesting game show. after the injection, haller left the room with a smile:
-

Racing against the US, China is developing 9 types of Covid-19 vaccine
the race for the development of the covid-19 vaccine is taking place in many countries. the united states has begun clinical trials and china is closely behind.
-

New discovery of a long-standing vaccine may help fight SARS-CoV-2
scientists are testing the bcg vaccine against tuberculosis to assess its ability to cope with the covid-19 epidemic.
-

DNA vaccine with immunotherapy can treat HPV
a new vaccine has the ability to produce an immune response in patients with head and neck squamous cell carcinoma, also known as hnscca, or in patients with hpv cancer tumors.
-

Dangerous malicious code, capable of self-mutating, attacking the vaccine manufacturing industry
a dangerous type of malicious code, capable of mutating itself to avoid security software, is attacking vaccine manufacturing and supply companies globally.
-

Frequently asked questions about flu vaccination
about 4 weeks after receiving the flu vaccine, the body forms the highest antibodies to prevent the disease, but a booster shot is needed every year.
-

Coronavirus vaccines: Drug trials, chloroquine and treatments for COVID-19
coronavirus vaccine candidates are already being trialled in animals and humans. plus, the cutting-edge drugs being developed to counter the pandemic.
-

Coronavirus chronicles: Here's some good news amid the dire reports
from vaccine progress to people uniting in friendship and solidarity, some positive covid-19 news to keep things in perspective.
-

Coronavirus treatments: Chloroquine, vaccines and the drugs fighting COVID-19
the most promising coronavirus vaccine candidates, treatments and the cutting-edge drugs being developed to counter the pandemic.